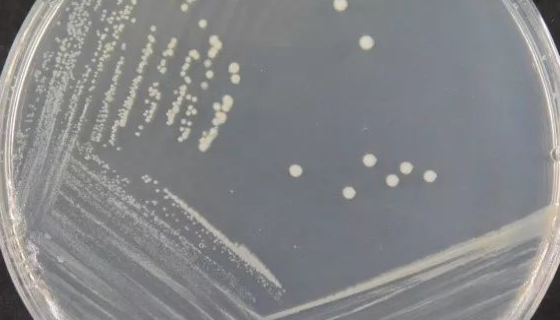
假交替单胞菌属的培养条件与注意事项！
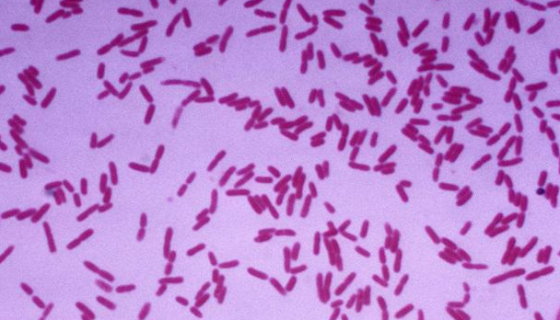
恶臭假单胞菌的耐药性与发酵条件及应用！

流产布鲁氏菌的特性与培养及使用范围!
流产布鲁氏菌属布鲁氏菌6个生物种中的牛种。革兰氏染色阴性,无...

星状诺卡氏菌的使用范围与培养方法及打管说明!
星状诺卡氏菌,杆菌和球菌状小体培养约10小时后伸长并形成芽管...

人口腔上皮细胞的分离方法与质量检测及注意事项!
人口腔上皮细胞分离自口腔黏膜组织;口腔上皮细胞是一种上皮细胞...

用来发酵泡菜和产乳酸的:魏斯氏菌属
魏斯氏菌属是Weissella属的微生物,原产地为中国。菌体...

明串珠菌属安瓿瓶冻干管打管说明书!
明串珠菌属Leucanostoc 链球菌科((Strepto...

争论贪噬菌的主要功能与培养方法及注意事项!
争论贪噬菌是Variovorax属的微生物,原产地为德国。菌...

小鼠卵巢上皮癌细胞+Luc的处理方法与培养步骤!
小鼠卵巢上皮癌细胞+Luc,为稳定转染Luc的细胞,随细胞传...
假交替单胞菌属的培养条件与注意事项!
假交替单胞菌属是Pseudoalteromonas属的微生物...
恶臭假单胞菌的耐药性与发酵条件及应用!
恶臭假单胞菌为无芽胞革兰阴性需氧细长杆菌,属假单胞菌属,一般...